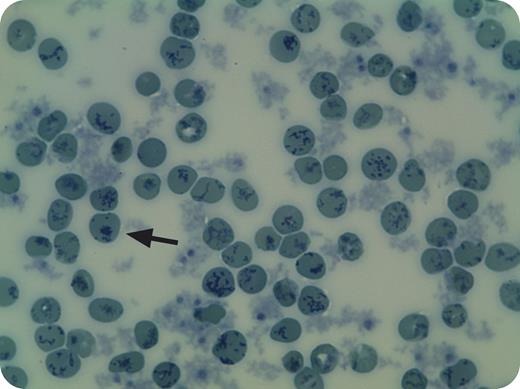
A 20-year-old splenectomized woman with hemolytic anemia, diagnosed at the age of 3 years with congenital dyserythropoietic anemia type I, was referred to our institution for re-examination of 2 unusual features: high red blood cell (RBC) pyruvate kinase (PK) activity and methemoglobinemia. On examination, she showed 3.5% methemoglobin and unusually high PK activity (45.0 U/gHb). Other RBC enzymes, notably hexokinase and glucose-6-phosphate dehydrogenase, also displayed high activities, suggestive of an RBC population of a very young age. Automated hematology analyzer measurements reported low reticulocyte numbers, but measurements were flagged as unreliable. We performed supravital staining with brilliant cresyl blue to determine reticulocyte numbers. Many cells displayed the blue-stained reticulum characteristic of reticulocytes. In addition, inclusion bodies reminiscent of Heinz bodies were noted (arrow). Together, this prompted us to re-evaluate the cause for hemolysis. Ultimately the patient was found to be heterozygous for a de novo p.Ala28Asp mutation in β-globin:Hb Volga. Substantial reticulocytosis, Heinz bodies, and methemoglobinemia are prominent features of this unstable hemoglobin variant. / Supravital staining is very rarely used in current hematological laboratory practice. In this case, it enabled us to reliably estimate reticulocyte numbers and provided a clue toward revision of the diagnosis in this patient.

A 20-year-old splenectomized woman with hemolytic anemia, diagnosed at the age of 3 years with congenital dyserythropoietic anemia type I, was referred to our institution for re-examination of 2 unusual features: high red blood cell (RBC) pyruvate kinase (PK) activity and methemoglobinemia. On examination, she showed 3.5% methemoglobin and unusually high PK activity (45.0 U/gHb). Other RBC enzymes, notably hexokinase and glucose-6-phosphate dehydrogenase, also displayed high activities, suggestive of an RBC population of a very young age. Automated hematology analyzer measurements reported low reticulocyte numbers, but measurements were flagged as unreliable. We performed supravital staining with brilliant cresyl blue to determine reticulocyte numbers. Many cells displayed the blue-stained reticulum characteristic of reticulocytes. In addition, inclusion bodies reminiscent of Heinz bodies were noted (arrow). Together, this prompted us to re-evaluate the cause for hemolysis. Ultimately the patient was found to be heterozygous for a de novo p.Ala28Asp mutation in β-globin:Hb Volga. Substantial reticulocytosis, Heinz bodies, and methemoglobinemia are prominent features of this unstable hemoglobin variant.
Supravital staining is very rarely used in current hematological laboratory practice. In this case, it enabled us to reliably estimate reticulocyte numbers and provided a clue toward revision of the diagnosis in this patient.
A 20-year-old splenectomized woman with hemolytic anemia, diagnosed at the age of 3 years with congenital dyserythropoietic anemia type I, was referred to our institution for re-examination of 2 unusual features: high red blood cell (RBC) pyruvate kinase (PK) activity and methemoglobinemia. On examination, she showed 3.5% methemoglobin and unusually high PK activity (45.0 U/gHb). Other RBC enzymes, notably hexokinase and glucose-6-phosphate dehydrogenase, also displayed high activities, suggestive of an RBC population of a very young age. Automated hematology analyzer measurements reported low reticulocyte numbers, but measurements were flagged as unreliable. We performed supravital staining with brilliant cresyl blue to determine reticulocyte numbers. Many cells displayed the blue-stained reticulum characteristic of reticulocytes. In addition, inclusion bodies reminiscent of Heinz bodies were noted (arrow). Together, this prompted us to re-evaluate the cause for hemolysis. Ultimately the patient was found to be heterozygous for a de novo p.Ala28Asp mutation in β-globin:Hb Volga. Substantial reticulocytosis, Heinz bodies, and methemoglobinemia are prominent features of this unstable hemoglobin variant.
Supravital staining is very rarely used in current hematological laboratory practice. In this case, it enabled us to reliably estimate reticulocyte numbers and provided a clue toward revision of the diagnosis in this patient.
For additional images, visit the ASH IMAGE BANK, a reference and teaching tool that is continually updated with new atlas and case study images. For more information visit http://imagebank.hematology.org.